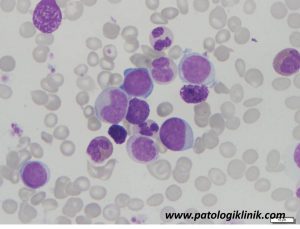

Mengatasi Pseudohipoksemia pada Hiperleukositosis

Pseudohipoksemia atau hipoksemia palsu adalah rendahnya kadar oksigen dalam darah secara in vitro yang tidak sesuai dengan kondisi dalam tubuh pasien sebenarnya. Keadaan ini sering ditemukan pada pasien dengan leukositosis yang sangat tinggi (hiperleukositosis) seperti pada pasien leukemia akut atau kronis; dan trombositosis seperti pada trombositosis esensial. Kesalahan interpretasi pseudohipoksemia sebagai hipoksemia sebenarnya dapat menyebabkan intervensi respiratorik yang tidak perlu, sehingga kita perlu mengetahui apa penyebab dan bagaimana cara mengatasinya.
Sebut saja Bapak Adi, usia 40 tahun, datang ke poliklinik dengan keluhan perut membesar sejak 6 bulan terakhir. Bapak Adi juga mengeluh mudah lelah dan sesak terutama setelah berjalan jauh. Pemeriksaan fisik menunjukkan jika Bapak Adi anemis dan terdapat pembesaran limpa (splenomegali) S7. Pemeriksaan laboratorium menunjukkan Hb 6,8 g/dl, leukosit 686.000 /ul, dan trombosit 212.000/ul dengan evaluasi apusan darah tepi tampak hiperleukositosis, basofilia, leukosit shift to the left, dan mieloblas 30%. Setelah dilakukan pemeriksaan sumsum tulang dan BCR-ABL, Bapak Adi didiagnosis menderita Leukemia Mielositik Kronis (CML) fase krisis blas.
Pada saat perawatan Bapak Adi mengeluh sesak, sehingga diberikan oksigen dan dilakukan pemeriksaan analisa gas darah arteri (BGA). Hasil yang keluar ternyata sangat mengagetkan dokter ruangan. Tekanan oksigen (pO2) Bapak Adi pada cetakan hasil lab hanya 3,5 mmHg (nilai normal 80-100 mmHg) dengan saturasi oksigen (satO2) 1,7% (nilai normal >95%). Karena hasil yang terlalu rendah, dilakukan pengambilan sampel darah arteri lagi dan dilakukan pemeriksaan ulang dengan perhatian khusus di alat BGA yang berbeda. Lagi-lagi nilai yang keluar masih sangat rendah, pO2 6,2 mmHg dan satO2 1,8%. Untuk mengkonfirmasi, dokter ruangan mengukur satO2 Bapak Adi dengan pulse oxymetry. Hasil satO2 dari pulse oxymetry 96%, jauh berbeda dengan alat BGA .

Dapat dilihat dari contoh kasus Bapak Adi di atas bahwa terdapat perbedaan nilai satO2 yang cukup menyolok antara alat BGA dengan pulse oximetry, satO2 alat BGA hanya 1,7% sedangkan pulse oximetry 96%. Hasil manakah yang dapat dipercaya? Jika dibandingkan nilai satO2 dengan kondisi klinis Bapak Adi, maka yang dapat dipercaya adalah hasil 96% dari pulse oxymetry. Jika memang benar satO2 pasien 1,7% maka bisa dipastikan kalau pasien tersebut sudah meninggal. Jadi hasil satO2 dari alat BGA tersebut adalah rendah palsu atau pseudohipoksemia.
Apa yang menyebabkan terjadinya pseudohipoksemia? Dari literatur disebutkan pseudohipoksemia sering terjadi pada pasien dengan hiperleukositosis. Mekanismenya sebagai berikut:
- Peningkatan konsumsi oksigen oleh leukosit. Metabolisme leukosit 45x lebih aktif dibanding trombosit. Semakin besar jumlah leukosit, maka penurunan oksigen makin cepat.
- Metabolisme sel blas pada pasien leukemia lebih aktif dibandingkan dengan sel lekosit normal, sehingga penurunan oksigen lebih cepat.
- Waktu tunda sampel sebelum dianalisis semakin lama, oksigen makin banyak yang dimetabolisme, maka saturasi oksigen makin rendah
- Jumlah leukosit yang terlalu tinggi dapat menyelubungi elektroda oksigen di alat BGA, mengganggu perpindahan molekul oksigen dari sampel darah ke elektroda pembacaan, sehingga hasil bacaan rendah palsu.
Terdapat beberapa pilihan cara mengatasi atau mengkonfirmasi pseudohipoksemia pada hiperleukositosis, yaitu:
- Menggunakan sampel plasma, sehingga leukosit tidak menyelubungi elektroda oksigen pada alat.
- Melakukan pre-cooling spuit sebelum dilakukan pengambilan sampel. Pre cooling mempercepat penurunan suhu sampel darah sehingga mengurangi konsumsi oksigen
- Penambahan sodium flouride dari vakutainer bertutup abu-abu ke dalam spuit BGA membantu mencegah penggunaan glukosa oleh leukosit.
- Menggunakan alat BGA POCT.
- Mengukur saturasi oksigen menggunakan pulse oximetry.
Dari berbagai alternatif pilihan di atas, penggunaan alat BGA POCT sebagai alternatif jarang digunakan, karena harga yang mahal dan biasanya rumah sakit hanya memiliki satu alat BGA. Pada kasus Bapak Adi di atas, penggunaan sampel plasma mungkin bisa dikerjakan, mengingat penyimpangan hasil satO2 pada kasus hiperleukositosis terjadi pada kadar leukosit lebih dari 500.000/ul (leukosit Bapak Adi 686.000 /ul). Penggunaan pulse oximetry tampaknya merupakan cara yang paling mudah, murah, dan cepat untuk mengetahui saturasi oksigen pasien hiperleukositosis dengan pseudohipoksemia.
Semoga bermanfaat.
Referensi:
Chen K, Puana RB, Price KJ, Koller CA, Nates JL. 2010. The role of point‑of‑care testing in the early diagnosis of pseudo‑hypoxemia in myeloproliferative disorders. Respir Care 55:777‑9.
Prasad KN, Manjunath P, Priya L, and Sasikumar S. 2012. Overcoming the problem of pseudohypoxemia in myeloproliferative disorders: Another trick in the bag. Indian Journal of Critical Care Medicine Vol 16(4): 210-212
Schmaier AH. 1980. Pseudohypoxemia due to leukemia and thrombocytosis. N Engl J Med;302:584.




![[Download] Pedoman Nasional Pelayanan Kedokteran Tata Laksana Thalassemia (KMK)](/content/images/uploads/2022/10/KMK.jpg)
![[Download] Pemeriksaan Laboratorium pada Thalassemia](/content/images/uploads/2022/09/cover-web-scaled.jpg)